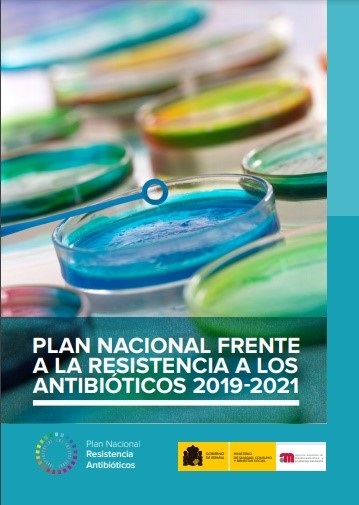

Spain: National plan to confront antibiotic resistance (Spanish)
2019-2021
1 January 2019
| Publication
Overview
Other Related Documents
Strategic Action Plan to reduce the risk of selection and dissemination of antibiotic resistance 2014-2018
WHO Team
National Action Plans and Monitoring and Evaluation (NPM)
Number of pages
21